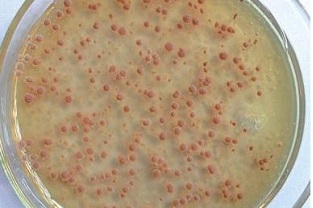
生物處理效果差（低溫對微生物菌種危害性很大）

DO是我們在控制生化反應(yīng)的一個重要條件。那我們知道呢DO 的濃度其實對我們氨氮也是會有影響的,也是會出現(xiàn)一些污水處理廠因為DO 沒有控制好,導致它的出水的氨氮就超標了。那么針...

【干貨】溫度過低導致的氨氮超標原因及處理辦法
溫度其實也是會對氨氮帶來影響的。我是經(jīng)常聽到我的同事都吐槽,就是到了冬天的時候,生化系統(tǒng)經(jīng)常不受控啊,偶爾出點毛病呢搞得人心惶惶。還有一些污水處理廠超標了,真的就...

水處理中如何投加藥劑,才能讓脫氮更有效?
脫氮是污水處理系統(tǒng)的一項重要功能,要保障脫氮除磷處理達標,很重要的一點就是要保證給微生物提供充足的有機物。又想馬兒跑得快,又想馬兒不吃草是不行的。...

10個入門水處理基礎(chǔ)知識分享!
化學需氧量(COD)是指廢水中能被氧化的物質(zhì)在被化學氧化劑氧化時,所需要的氧量,以氧的毫克/升作為單位。它是目前用來測定廢水中有機物含量的一種最常用的手段。COD分析中常用...